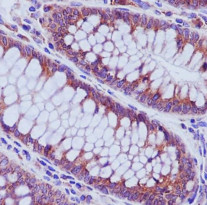

ARG41894
anti-Rab5 antibody
anti-Rab5 antibody for IHC-Formalin-fixed paraffin-embedded sections,Western blot and Human,Mouse,Rat
概述
| 产品描述 | Rabbit Polyclonal antibody recognizes Rab5 |
|---|---|
| 反应物种 | Hu, Ms, Rat |
| 应用 | IHC-P, WB |
| 宿主 | Rabbit |
| 克隆 | Polyclonal |
| 同位型 | IgG |
| 靶点名称 | Rab5 |
| 抗原物种 | Human |
| 抗原 | Synthetic peptide of Human Rab5. |
| 偶联标记 | Un-conjugated |
| 別名 | Ras-related protein Rab-5A; RAB5 |
应用说明
| 应用建议 |
|
||||||
|---|---|---|---|---|---|---|---|
| 应用说明 | * The dilutions indicate recommended starting dilutions and the optimal dilutions or concentrations should be determined by the scientist. | ||||||
| 阳性对照 | MCF7 | ||||||
| 实际分子量 | ~ 24 kDa |
属性
| 形式 | Liquid |
|---|---|
| 纯化 | Affinity purified. |
| 缓冲液 | PBS (pH 7.4), 150 mM NaCl, 0.02% Sodium azide and 50% Glycerol. |
| 抗菌剂 | 0.02% Sodium azide |
| 稳定剂 | 50% Glycerol |
| 存放说明 | For continuous use, store undiluted antibody at 2-8°C for up to a week. For long-term storage, aliquot and store at -20°C. Storage in frost free freezers is not recommended. Avoid repeated freeze/thaw cycles. Suggest spin the vial prior to opening. The antibody solution should be gently mixed before use. |
| 注意事项 | For laboratory research only, not for drug, diagnostic or other use. |
生物信息
| 数据库连接 | |
|---|---|
| 基因名称 | RAB5A |
| 全名 | RAB5A, member RAS oncogene family |
| 生物功能 | The small GTPases Rab are key regulators of intracellular membrane trafficking, from the formation of transport vesicles to their fusion with membranes. Rabs cycle between an inactive GDP-bound form and an active GTP-bound form that is able to recruit to membranes different sets of downstream effectors directly responsible for vesicle formation, movement, tethering and fusion. RAB5A is required for the fusion of plasma membranes and early endosomes. Contributes to the regulation of filopodia extension. [UniProt] |
| 细胞定位 | Cell membrane; Lipid-anchor; Cytoplasmic side. Early endosome membrane; Lipid-anchor. Melanosome. Cytoplasmic vesicle. Cell projection, ruffle. Membrane. Cytoplasm, cytosol. Cytoplasmic vesicle, phagosome membrane. Endosome membrane. Note=Enriched in stage I melanosomes (PubMed:17081065). Alternates between membrane-bound and cytosolic forms (Probable). [UniProt] |
| 预测分子量 | 24 kDa |
检测图片 (2) Click the Picture to Zoom In